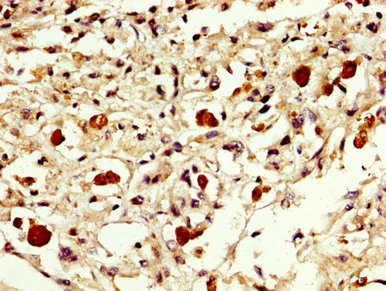
CSB-PA007889LA01HU

EXOSC10
EXOSC10,即外泌體組分10,別名RRP6、PMSCL、Rrp6p、PM-Scl、PMSCL2、PM/Scl-100等。它是一種核糖核酸外切酶,參與RNA的代謝過程,包括5.8S rRNA的成熟和通過端粒酶對端粒維持的負調(diào)節(jié)。EXOSC10在胞質溶膠、核腔和轉錄活性染色質中都有分布,是核外泌體(RNase復合物)的一部分。其作用機制涉及啟用3'-5'-核糖核酸外切酶活性,通過降解特定RNA分子來調(diào)控基因表達。EXOSC10對維持基因表達的穩(wěn)定性和參與細胞周期調(diào)控具有重要作用,其異常表達與多種疾病相關,包括肝病、癌癥和神經(jīng)系統(tǒng)疾病等。
熱銷產(chǎn)品
EXOSC10 Antibody (CSB-PA007889LA01HU)
驗證數(shù)據(jù)
IHC image of CSB-PA007889LA01HU diluted at 1:300 and staining in paraffin-embedded human melanoma performed on a Leica BondTM system. After dewaxing and hydration, antigen retrieval was mediated by high pressure in a citrate buffer (pH 6.0). Section was blocked with 10% normal goat serum 30min at RT. Then primary antibody (1% BSA) was incubated at 4°C overnight. The primary is detected by a biotinylated secondary antibody and visualized using an HRP conjugated SP system.
EXOSC10 Antibodies
EXOSC10 for Homo sapiens (Human)
| 產(chǎn)品貨號 | 產(chǎn)品名稱 | 種屬反應性 | 應用類型 |
|---|---|---|---|
| CSB-PA007889GA01HU | EXOSC10 Antibody | Human,Mouse,Rat | ELISA,IHC |
| CSB-PA007889LA01HU | EXOSC10 Antibody | Human | ELISA, IHC |
| CSB-PA007889LB01HU | EXOSC10 Antibody, HRP conjugated | Human | ELISA |
| CSB-PA007889LC01HU | EXOSC10 Antibody, FITC conjugated | Human | |
| CSB-PA007889LD01HU | EXOSC10 Antibody, Biotin conjugated | Human | ELISA |
















